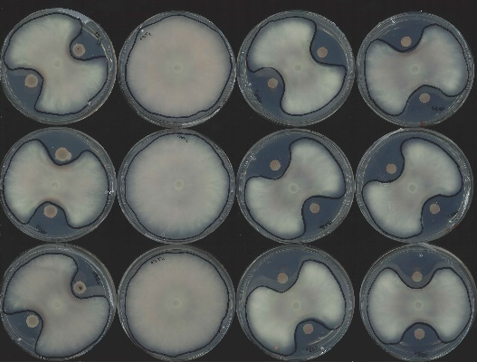

Vous le savez, la Clinique des plantes est une des plus vieilles entités de notre asbl CORDER. Forte de son expérience, elle continue de proposer un service d’analyses, de conseils et de mise en place de projets sur mesure dans le domaine de la protection des plantes pour ses clients et partenaires.
APPI , un outil pour détecter les maladies fréquentes sur les plantes
Son travail quotidien est donc d’apporter une approche qui lie le monde de la recherche et le monde agricole. C’est en ce sens qu’elle a contribué au développement de la plateforme gratuite APPI , plateforme qu’elle alimente régulièrement grâce à son expertise.
Mais APPI , qu’est-ce que c’est ? APPI signifie "application pour une protection intégrée des plantes". C’est un outil en ligne qui permet d’identifier des maladies qui se présentent fréquemment sur les grandes cultures, les arbres fruitiers, les plantes potagères ou ornementales. L’outil est intuitif et simple d’utilisation. En quelques clics seulement, vous pourrez ainsi détecter la maladie ou le ravageur présent sur votre plante. Des conseils vous seront donnés pour lutter contre les maladies des plantes souvent rencontrées dans nos régions grâce aux fiches développées à cet effet.
Envie d’aller y faire un tour ? Ça se passe sur APPI.be
Toujours pas de diagnostic ?
Certaines maladies étant plus difficiles à identifier, la Clinique des Plantes maintient ses travaux de recherches pour poser des diagnostics spécifiques à chaque cas.
Nos derniers cas en quelques photos :
Besoins de recherches spécifiques
Outre le développement de cette plateforme en ligne et du diagnostic sur mesure, elle continue de répondre aux besoins de recherches spécifiques de ses clients en lien avec la santé des végétaux : test d’efficacité de produits phytopharmaceutiques en conditions contrôlées, analyses de la qualité phytosanitaire (végétaux, eaux, solutions nutritives), essais en serres, détection moléculaire d’organismes phytopathogènes, …
Les dernières analyses en quelques photos :
Suivi régional de maladies de grandes cultures
Enfin, la Clinique des Plantes participe activement au suivi régional de certaines maladies de grandes cultures. C’est ainsi que cet automne, l’équipe a pris part aux « observations des ravageurs d’automne » du CePiCOP . Ces observations proposent des avertissements hebdomadaires en céréales, oléagineux et protéagineux en période critique.
Vous avez encore des questions ? Pour toute demande de devis ou autre question spécifique à la Clinique des Plantes, n’hésitez pas à nous contacter au 010 47 37 52 de 9h à 17h ou par mail via cliniquedesplantes@uclouvain.be
Et pour ne rater aucune actualité de l’asbl CORDER, abonnez-vous à notre newsletter !